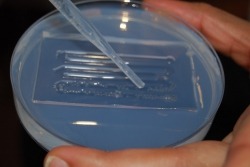
Z-MOLD

Zebrafish Microinjection and Transplantation Molds

A simpler method for handling zebrafish embryos
Mold your agarose, pipette in your embryos and watch them auto-align in the grooves. Z-MOLDS Microinjection and Transplantation Molds (4 per kit) are specifically designed for zebrafish research.
See the current Data Sheet.
Features
- For high throughput microinjection research
- Make impressions in agarose gel to facilitate embryo alignment
- Four molds per kit
- Reusable
Benefits
- Organizes and immobilizes embryos for microinjection
Applications
- Zebrafish research
The molds are turned up-side down and placed in liquid agarose gel and are easily removed once it has solidified. The embryos may be pipetted into the grooves made by the mold in the agarose. The width and design of the molds enable the embryos to self-align.

Proteomics and Large Screening
This mold is designed for injecting many embryos-up to 1000. The grooves made by the mold in the agarose gel enable the embryos to self align.



Xenograft and Larval Injection
This mold is designed for larval injections. The sloped ridges make perfect angles in the agarose gel, which then makes it easier to do microinjections in the larvae.



Standard Microinjection
This mold is designed for increasing the speed of doing microinjections. Simply turn the petri dish as you are injecting.



Transplantation
This mold is designed for blastomere transplantation.



| SKU | Z-MOLDS |
|---|
Kitambi SS, Toledo EM, Usoskin D, Wee S, Harisankar A, Svensson R, Sigmundsson, K, Kalderén C, Niklasson M, Kundu S, Aranda S, Westermark B, Uhrbom L, Andäng M, Damberg P, Nelander S, Arenas E, Artursson P, Walfridsson J, Forsberg Nilsson K, Hammarström LG, Ernfors P. Vulnerability of glioblastoma cells to catastrophic vacuolization and death induced by a small molecule. Cell. 2014 Apr 10;157(2):313-28.
Kitambi SS, Nilsson ES, Sekyrova P, Ibarra C, Tekeoh GN, Andäng M, Ernfors P, Uhlén P. Small molecule screening platform for assessment of cardiovascular toxicity on adult zebrafish heart. BMC Physiol. 2012 Mar 26;12:3.
Chandrasekar G, Vesterlund L, Hultenby K, Tapia-Páez I, Kere J. The zebrafish orthologue of the dyslexia candidate gene DYX1C1 is essential for cilia growth and function. PLoS One. 2013 May 1;8(5):e63123.

























